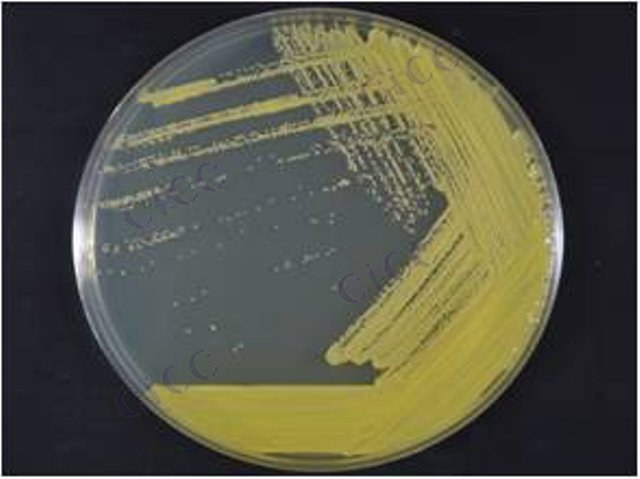
Micrococcus lylae

Micrococcus lylae
-
Micrococcus lylae
CICC 23990 | 见证书
-
Micrococcus lylae ATCC 27566 Culti-Loop Micrococcus lylae ATCC® 27566™
R4604010 | 5支/包
-
里拉微球菌 Micrococcus lylae
BNCC337476 | 冻干粉;斜面;菌液;平板
-
Micrococcus luteus
BNCC136226 | 冻干粉;斜面;菌液;平板
-
Micrococcus flavus
BNCC137068 | 冻干粉;斜面;菌液;平板
-
Micrococcus luteus
BNCC138438 | 冻干粉;斜面;菌液;平板
-
Micrococcus luteus
BNCC359105 | 冻干粉;斜面;菌液;平板

说明书下载: 菌种说明书 打管说明书
您正在浏览的产品:里拉微球菌 Micrococcus lylae CICC 23993
手机版:里拉微球菌 Micrococcus lylae CICC 23993
本公司销售的所有产品仅供实验科研使用,不用于人体及临床诊断。